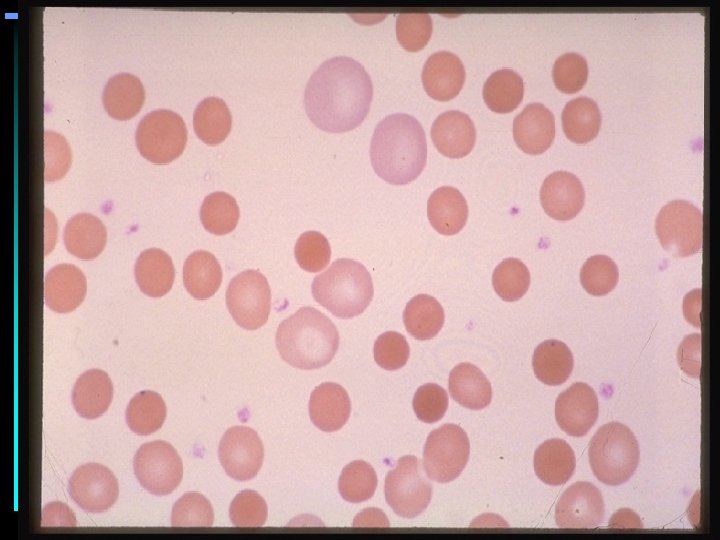
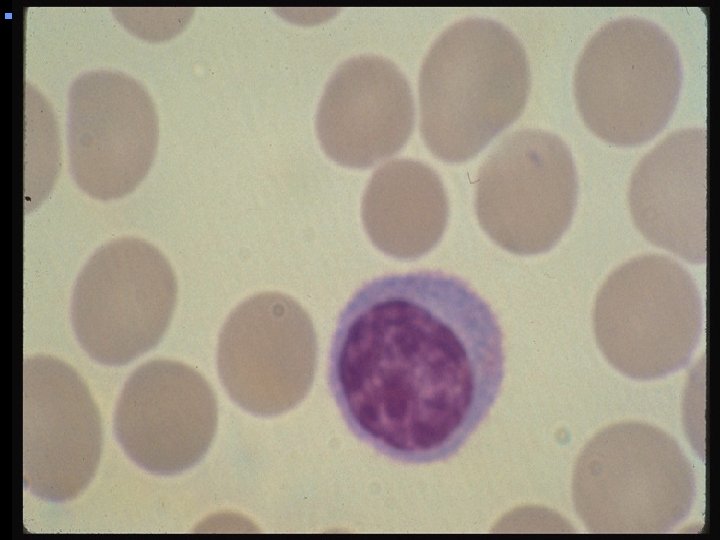
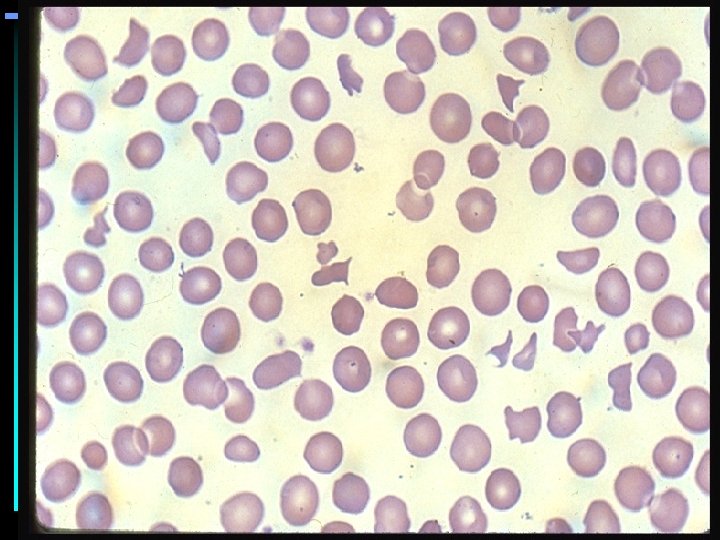

HEMOLYTIC ANEMIAS HEMOLYTIC ANEMIA Anemia of increased destruction

- Slides: 44
HEMOLYTIC ANEMIAS
HEMOLYTIC ANEMIA • Anemia of increased destruction – Normochromic, normochromic anemia – Shortened RBC survival – Reticulocytosis - Response to increased RBC destruction – Increased indirect bilirubin – Increased LDH
HEMOLYTIC ANEMIA Testing • Absent haptoglobin • Hemoglobinuria • Hemoglobinemia
HEMOLYTIC ANEMIA Causes • INTRACORPUSCULAR HEMOLYSIS – Membrane Abnormalities – Metabolic Abnormalities – Hemoglobinopathies • EXTRACORPUSCULAR HEMOLYSIS – Nonimmune – Immune
HEMOLYTIC ANEMIA Membrane Defects • Microskeletal defects – Hereditary spherocytosis • Membrane permeability defects – Hereditary stomatocytosis • Increased sensitivity to complement – Paroxysmal nocturnal hemoglobinuria
RED CELL CYTOSKELETON
HEREDITARY SPHEROCYTOSIS • Defective or absent spectrin molecule • Leads to loss of RBC membrane, leading to spherocytosis • Decreased deformability of cell • Increased osmotic fragility • Extravascular hemolysis in spleen
SPLENIC ARCHITECTURE
HEREDITARY SPHEROCYTOSIS Osmotic Fragility
Paroxysmal Nocturnal Hemoglobinuria • Clonal cell disorder • Ongoing Intra- & Extravascular hemolysis; classically at night • Testing – Acid hemolysis (Ham test) – Sucrose hemolysis – CD-59 & CD-55 negative • Acquired deficit of GPI-Associated proteins (including Decay Activating Factor)
GPI BRIDGE
Paroxysmal Nocturnal Hemoglobinuria GPI Proteins • GPI links a series of proteins to outer leaf of cell membrane via phosphatidyl inositol bridge, with membrane anchor via diacylglycerol bridge • PIG-A gene, on X-chromosome, codes for synthesis of this bridge; multiple defects known to cause lack of this bridge • Absence of decay accelerating factor leads to failure to inactivate complement & thereby to increased cell lysis
HEMOLYTIC ANEMIA Membrane abnormalities - Enzymopathies • Deficiencies in Hexose Monophosphate Shunt – Glucose 6 -Phosphate Dehydrogenase Deficiency • Deficiencies in the EM Pathway – Pyruvate Kinase Deficiency
G 6 PD DEFICIENCY – Function of G 6 PD
Glucose 6 -Phosphate Dehydrogenase Functions • Regenerates NADPH, allowing regeneration of glutathione • Protects against oxidative stress • Lack of G 6 PD leads to hemolysis during oxidative stress – Infection – Medications – Fava beans • Oxidative stress leads to Heinz body formation, extravascular hemolysis
Glucose 6 -Phosphate Dehydrogenase Different Isozymes Level needed for protection vs ordinary oxidative stress
HEMOLYTIC ANEMIA Causes • INTRACORPUSCULAR HEMOLYSIS – Membrane Abnormalities – Metabolic Abnormalities – Hemoglobinopathies • EXTRACORPUSCULAR HEMOLYSIS – Nonimmune – Immune
EXTRACORPUSCULAR HEMOLYSIS Nonimmune • • • Mechanical Infectious Chemical Thermal Osmotic
Microangiopathic Hemolytic Anemia Causes • Vascular abnormalities – Thrombotic thrombocytopenic purpura – Renal lesions • • Malignant hypertension Glomerulonephritis Preeclampsia Transplant rejection – Vasculitis • • Polyarteritis nodosa Rocky mountain spotted fever Wegener’s granulomatosis Scleroderma renal crisis
Microangiopathic Hemolytic Anemia Causes - #2 – Vascular abnormalities • AV Fistula • Cavernous hemangioma • Intravascular coagulation predominant – Abruptio placentae – Disseminated intravascular coagulation
IMMUNE HEMOLYTIC ANEMIA General Principles • All require antigen-antibody reactions • Types of reactions dependent on: – – – Class of Antibody Number & Spacing of antigenic sites on cell Availability of complement Environmental Temperature Functional status of reticuloendothelial system • Manifestations – Intravascular hemolysis – Extravascular hemolysis
IMMUNE HEMOLYTIC ANEMIA General Principles - 2 • • • Antibodies combine with RBC, & either 1. Activate complement cascade, &/or 2. Opsonize RBC for immune system If 1, if all of complement cascade is fixed to red cell, intravascular cell lysis occurs If 2, &/or if complement is only partially fixed, macrophages recognize Fc receptor of Ig &/or C 3 b of complement & phagocytize RBC, causing extravascular RBC destruction
IMMUNE HEMOLYTIC ANEMIA Coombs Test - Direct • Looks for immunoglobulin &/or complement of surface of red blood cell (normally neither found on RBC surface) • Coombs reagent - combination of anti-human immunoglobulin & anti-human complement • Mixed with patient’s red cells; if immunoglobulin or complement are on surface, Coombs reagent will link cells together and cause agglutination of RBCs
IMMUNE HEMOLYTIC ANEMIA Coombs Test - Indirect • Looks for anti-red blood cell antibodies in the patient’s serum, using a panel of red cells with known surface antigens • Combine patient’s serum with cells from a panel of RBC’s with known antigens • Add Coombs’ reagent to this mixture • If anti-RBC antigens are in serum, agglutination occurs
HEMOLYTIC ANEMIA - IMMUNE • Drug-Related Hemolysis • Alloimmune Hemolysis – Hemolytic Transfusion Reaction – Hemolytic Disease of the Newborn • Autoimmune Hemolysis – Warm autoimmune hemolysis – Cold autoimmune hemolysis
IMMUNE HEMOLYSIS Drug-Related • Immune Complex Mechanism – Quinidine, Quinine, Isoniazid • “Haptenic” Immune Mechanism – Penicillins, Cephalosporins • True Autoimmune Mechanism – Methyldopa, L-DOPA, Procaineamide, Ibuprofen
DRUG-INDUCED HEMOLYSIS Immune Complex Mechanism • Drug & antibody bind in the plasma • Immune complexes either – Activate complement in the plasma, or – Sit on red blood cell • Antigen-antibody complex recognized by RE system • Red cells lysed as “innocent bystander” of destruction of immune complex • REQUIRES DRUG IN SYSTEM
DRUG-INDUCED HEMOLYSIS Haptenic Mechanism • Drug binds to & reacts with red cell surface proteins • Antibodies recognize altered protein, ± drug, as foreign • Antibodies bind to altered protein & initiate process leading to hemolysis
DRUG-INDUCED HEMOLYSIS True Autoantibody Formation • Certain drugs appear to cause antibodies that react with antigens normally found on RBC surface, and do so even in the absence of the drug
DRUG-INDUCED HEMOLYSIS Mechanisms
ALLOIMUNE HEMOLYSIS Hemolytic Transfusion Reaction • Caused by recognition of foreign antigens on transfused blood cells • Several types – Immediate Intravascular Hemolysis (Minutes) - Due to preformed antibodies; life-threatening – Slow extravascular hemolysis (Days) - Usually due to repeat exposure to a foreign antigen to which there was a previous exposure; usually only mild symptoms – Delayed sensitization - (Weeks) - Usually due to 1 st exposure to foreign antigen; asymptomatic
INCOMPATIBLE RBC TRANSFUSION Rate of Hemolysis
ALLOIMMUNE HEMOLYSIS Testing Pre-transfusion • ABO & Rh Type of both donor & recipient • Antibody Screen of Donor & Recipient, including indirect Coombs • Major cross-match by same procedure (recipient serum & donor red cells)
ALLOIMMUNE HEMOLYSIS Hemolytic Disease of the Newborn • Due to incompatibility between mother negative for an antigen & fetus/father positive for that antigen. Rh incompatibility, ABO incompatibility most common causes • Usually occurs with 2 nd or later pregnancies • Requires maternal Ig. G antibodies vs. RBC antigens in fetus
ALLOIMMUNE HEMOLYSIS Hemolytic Disease of the Newborn - #2 • Can cause severe anemia in fetus, with erythroblastosis and heart failure • Hyperbilirubinemia can lead to severe brain damage (kernicterus) if not promptly treated • HDN due to Rh incompatibility can be almost totally prevented by administration of anti-Rh D to Rh negative mothers after each pregnancy
AUTOIMMUNE HEMOLYSIS • Due to formation of autoantibodies that attack patient’s own RBC’s • Type characterized by ability of autoantibodies to fix complement & site of RBC destruction • Often associated with either lymphoproliferative disease or collagen vascular disease
AUTOIMMUNE HEMOLYSIS Warm Type • • Usually Ig. G antibodies Fix complement only to level of C 3, if at all Immunoglobulin binding occurs at all temps Fc receptors/C 3 b recognized by macrophages; therefore, • Hemolysis primarily extravascular • 70% associated with other illnesses • Responsive to steroids/splenectomy
AUTOIMMUNE HEMOLYSIS Cold Type • • Most commonly Ig. M mediated Antibodies bind best at 30º or lower Fix entire complement cascade Leads to formation of membrane attack complex, which leads to RBC lysis in vasculature • Typically only complement found on cells • 90% associated with other illnesses • Poorly responsive to steroids, splenectomy; responsive to plasmapheresis
HEMOLYTIC ANEMIA Summary • Myriad causes of increased RBC destruction • Marrow function usually normal • Often requires extra folic acid to maintain hematopoiesis • Anything that turns off the bone marrow can result in acute, life-threatening anemia